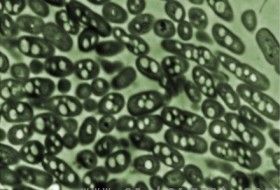

光在该实验中发挥了关键作用,它能转换基因的表达。这些特定基因对光敏感,光可以触发或抑制其表达,改造过的酵母可实现在生产乙醇和异丁醇之间交替。研究人员通过基因工程来抑制酵母的生长,产生大量的异丁醇,但高浓度的异丁醇会杀死酵母,因此研究者通过基因工程和光线组合来优化异丁醇生产。首先,研究人员将蓝光可控制的海洋细菌的修饰基因置于酵母的DNA中,然后利用光线开启反应过程,激活酵素,酵母消耗葡萄糖,分泌乙醇,自然地生长和繁殖。在此期间生产异丁醇的酶不起作用。将酵母转向黑暗,关闭乙醇生产酶,为异丁醇的产生腾出空间。研究人员通过每隔几小时发射一阵蓝光来让细胞生长,避免异丁醇的过度累积,来找到光明与黑暗的正确平衡点。
较之于基因工程或化学添加剂,使用光控制酵母的化学生产有以下几个优势。首先,光线比大多数的替代品更快、更便宜。光是可调节的,在发酵过程中可以随时切换细胞的功能。另外,光可以作用于特定基因而不影响细胞的其他部分。